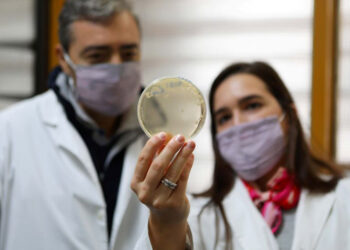
CONICET: PROPONEN REUTILIZAR DESECHOS DE LA PRODUCCIÓN DE QUESOS

LA UNCUYO LLEGÓ AL LIBRO “CRÓNICA DE LA LENGUA ESPAÑOLA” DE LA RAE
7 noviembre, 2025
VUELVE EL TALENTO AL CICLO MICRÓFONO ABIERTO DE LA ESCUELA DE MÚSICA
7 noviembre, 2025
¡HACIA LAS SEMIFINALES DE LA LIGA PROVINCIAL UNIVERSITARIA!
7 noviembre, 2025